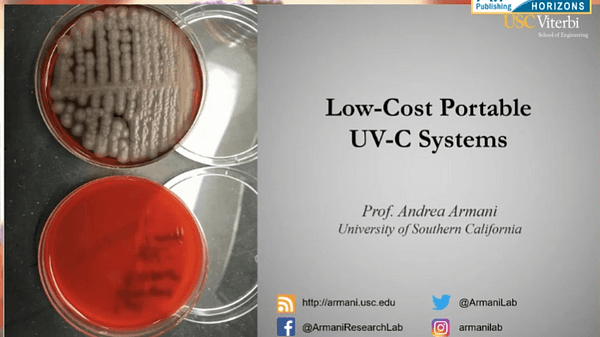
Low-Cost Portable UV-C Systems - Andrea M. Armani

Premium content
Access to this content requires a subscription. You must be a premium user to view this content.
Monthly subscription - $9.99Pay per view - $4.99Access through your institutionLogin with Underline account
Need help?
Contact us
Would you like to see your presentation here, made available to a global audience of researchers?
Add your own presentation or have us affordably record your next conference.